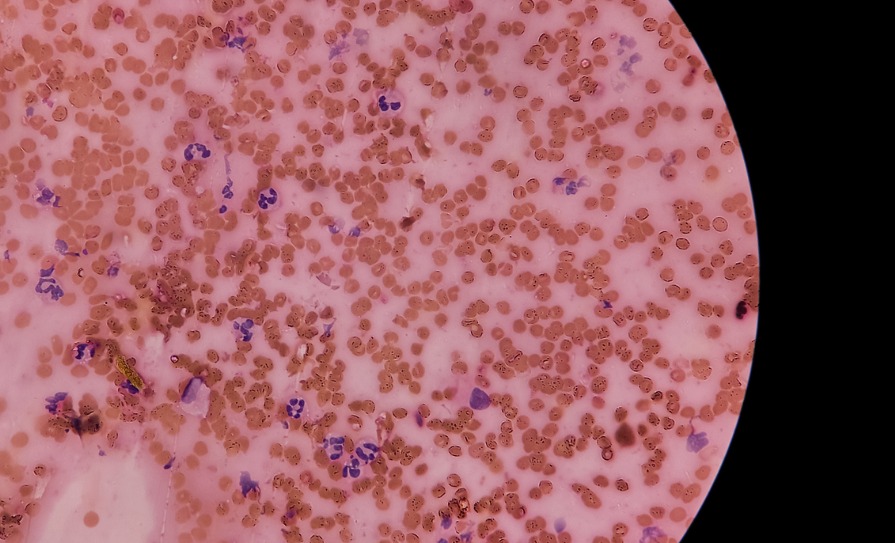

References
Data available at www.ncri.ie
Cervical cancer: Estimated incidence, mortality, and prevalence worldwide in 2012. International Agency for Research on Cancer and World Health Organisation. 2012. Available at: http://globocan.iarc.fr/Pages/fact_sheets_cancer.aspx
Jemal A, Bray F, Center MM, et al. Global cancer statistics. CA Cancer J Clin. 2011;61:69-90
Kjaer SK, Frederiksen K, Munk C, Iftner T. Long-term absolute risk of cervical intraepithelial neoplasia grade 3 or worse following human papillomavirus infection: Role of persistence. J Natl Cancer Inst. 2010;102:1478-1488
Rodriguez AC, Schiffman M, Herrero R, et al. Longitudinal study of human papillomavirus persistence and cervical intraepithelial neoplasia grade 2/3: Critical role of duration of infection. J Natl Cancer Inst. 2010;102:315-324
Villa LL, Costa RL, Petta CA, et al. Prophylactic quadrivalent human papillomavirus (types 6, 11, 16, and 18) L1 virus-like particle vaccine in young women: A randomised double-blind placebo-controlled multicentre phase II efficacy trial. Lancet Oncol. 2005;6:271-278
Ault KA. Effect of prophylactic human papillomavirus L1 virus-like particle vaccine on risk of cervical intraepithelial neoplasia grade 2, grade 3, and adenocarcinoma in situ: A combined analysis of four randomised clinical trials. Lancet. 2007;369:1861-1868
Quadrivalent vaccine against human papillomavirus to prevent high grade cervical lesions. N Engl J Med. 2007;356:1915-1927
Bray F, Carstensen B, Moller H, et al. Incidence trends of adenocarcinoma of the cervix in 13 European countries. Cancer Epidemiol Biomarkers Prev. 2005;14:2191-2199
Castellsague X, Diaz M, de Sanjose S, et al. Worldwide human papillomavirus etiology of cervical adenocarcinoma and its co-factors: Implications for screening and prevention. J Natl Cancer Inst. 2006;98:303-315
Sasieni P, Castanon A, Cuzick J. Screening and adenocarcinoma of the cervix. Int J Cancer. 2009;125:525-529
Comparison of risk factors for invasive squamous cell carcinoma and adenocarcinoma of the cervix: Collaborative reanalysis of individual data on 8,097 women with squamous cell carcinoma and 1,374 women with adenocarcinoma from 12 epidemiological studies. Int J Cancer. 2007;120:885-891
Dugue PA, Rebolj M, Garred P, Lynge E. Immunosuppression and risk of cervical cancer. Expert Rev Anticancer Ther. 2013;13:29-42
Bentivegna E, Gouy S, Maulard A, et al. Oncological outcomes after fertility-sparing surgery for cervical cancer: A systematic review. Lancet Oncol. 2016;17:e240-253
Viswanathan AN, Deavers MT, Jhingran A, et al. Small cell neuroendocrine carcinoma of the cervix: Outcome and patterns of recurrence. Gynecol Oncol. 2004;93:27-33
Young RH, Clement PB. Endocervical adenocarcinoma and its variants: Their morphology and differential diagnosis. Histopathology. 2002;41:185-207
Plante M, Gregoire J, Renaud MC, Roy M. The vaginal radical trachelectomy: An update of a series of 125 cases and 106 pregnancies. Gynecol Oncol. 2011;121:290-297
Wethington SL, Cibula D, Duska LR, et al. An international series on abdominal radical trachelectomy: 101 patients and 28 pregnancies. Int J Gynecol Cancer. 2012;22:1251-1257
Shepherd JH, Spencer C, Herod J, Ind TEJ. Radical vaginal trachelectomy as a fertility-sparing procedure in women with early-stage cervical cancer-cumulative pregnancy rate in a series of 123 women. BJOG. 2006;113:719-724
Park JY, Kim DY, Suh DS, et al. Reproductive outcomes after laparoscopic radical trachelectomy for early-stage cervical cancer. J Gynecol Oncol. 2014;25:9-13
Gizzo S, Ancona E, Saccardi C, et al. Radical trachelectomy: The first step of fertility preservation in young women with cervical cancer (Review). Oncol Rep. 2013;30:2545-2554
Thomas GM, Dembo AJ, Myhr T, et al. Long-term results of concurrent radiation and chemotherapy for carcinoma of the cervix recurrent after surgery. Int J Gynecol Cancer. 1993;3:193-198
Sardain H, Lavoue V, Redpath M, et al. Curative pelvic exenteration for recurrent cervical carcinoma in the era of concurrent chemotherapy and radiation therapy. A systematic review. Eur J Surg Oncol. 2015;41:975-985
Chiantera V, Rossi M, De Iaco P, et al. Morbidity after pelvic exenteration for gynaecological malignancies: A retrospective multicentric study of 230 patients. Int J Gynecol Cancer. 2014;24:156-164
Morley GW, Hopkins MP, Lindenauer SM, Roberts JA. Pelvic exenteration, University of Michigan: 100 patients at five years. Obstet Gynecol. 1989;74:934-943
de Gregorio N, de Gregorio A, Ebner F, et al. Pelvic exenteration as ultimate ratio for gynaecological cancers: Single-centre analyses of 37 cases. Arch Gynecol Obstet. 2019;300:161-8
Bacalbasa N, Balescu I, Vilcu M, et al. Pelvic exenteration for locally advanced and relapsed pelvic malignancies – an analysis of 100 cases. In Vivo. 2019;33:2205-10
Ruscito I, Gasparri ML, Braicu EI, et al. Sentinel node mapping in cervical and endometrial cancer: Indocyanine green versus other conventional Dyes-A meta-analysis. Ann Surg Oncol. 2016;23:3749-3756
Frumovitz M, Plante M, Lee PS, et al. The FILM Trial: A randomised phase III multicenter study assessing near infrared fluorescence in the identification of sentinel lymph nodes (SLN) [Abstract]. Gynecol Oncology. 2018;149:7
Frumovitz M, Querleu D, Gil-Moreno A, et al. Lymphadenectomy in locally advanced cervical cancer study (LiLACS): Phase III clinical trial comparing surgical with radiologic staging in patients with stages IB2-IVA cervical cancer. J Minim Invasive Gynecol. 2014;21:3-8
Ramirez PT, Frumovitz M, Pareja R, et al. Minimally invasive versus abdominal radical hysterectomy for cervical cancer. N Engl J Med. 2018 Nov 15;379(20):1895-1904
Melamed A, Margul DJ, Chen L, et al. Survival after minimally invasive radical hysterectomy for early-stage cervical cancer. N Engl J Med. 2018 Nov 15;379(20):1905-1914
Margul DJ, Yang J, Seagle BL, et al. Outcomes and costs of open, robotic, and laparoscopic radical hysterectomy for stage IB1 cervical cancer. J Clin Oncol. 2018;36:5502-5502
Gaffney DK, Erickson-Wittmann BA, Jhingran A, et al. ACR appropriateness criteria(R) on advanced cervical cancer expert panel on radiation oncology-gynaecology. Int J Radiat Oncol Biol Phys. 2011;81:609-614.
Monk BJ, Tewari KS, Koh W-J. Multimodality therapy for locally advanced cervical carcinoma: State of the art and future directions. J Clin Oncol. 2007;25:2952-2965
Chemoradiotherapy for cervical cancer meta-analysis C. Reducing uncertainties about the effects of chemoradiotherapy for cervical cancer: A systematic review and meta-analysis of individual patient data from 18 randomised trials. J Clin Oncol. 2008;26:5802-5812
Pearcey R, Miao Q, Kong W, et al. Impact of adoption of chemoradiotherapy on the outcome of cervical cancer in Ontario: Results of a population-based cohort study. J Clin Oncol. 2007;25:2383-2388
Pahisa J, Martinez-Roman S, Martinez-Zamora MA, et al. Laparoscopic ovarian transposition in patients with early cervical cancer. Int J Gynecol Cancer. 2008;18:584-589
Morice P, Juncker L, Rey A, et al. Ovarian transposition for patients with cervical carcinoma treated by radiosurgical combination. Fertil Steril. 2000;74:743-748
Pfaendler KS, Wenzel L, Mechanic MB, Penner KR. Cervical cancer survivorship: Long-term quality-of-life and social support. Clin Ther. 2015 Jan 1;37(1):39-48
Eifel PJ, Levenback C, Wharton JT, Oswald MJ. Time course and incidence of late complications in patients treated with radiation therapy for FIGO stage IB carcinoma of the uterine cervix. Int J Radiat Oncol Biol Phys. 1995;32:1289-1300
Forrest JL, Ackerman I, Barbera L, et al. Patient outcome study of concurrent chemoradiation, external beam radiotherapy, and high-dose rate brachytherapy in locally advanced carcinoma of the cervix. Int J Gynecol Cancer. 2010;20:1074-1078
Perez CA, Grigsby PW, Lockett MA, et al. Radiation therapy morbidity in carcinoma of the uterine cervix: Dosimetric and clinical correlation. Int J Radiat Oncol Biol Phys. 1999;44:855-866
Monk BJ, Sill MW, McMeekin DS, et al. Phase III trial of four cisplatin-containing doublet combinations in stage IVB, recurrent, or persistent cervical carcinoma: A Gynaecological Oncology Group study. J Clin Oncol. 2009;27:4649–55
Tewari KS, Sill MW, Penson RT, et al. Bevacizumab for advanced cervical cancer: Final overall survival and adverse event analysis of a randomised, controlled, open-label, phase 3 trial (Gynaecological Oncology Group 240). Lancet. 2017;390:1654-63
Frenel JS, Le Tourneau C, O’Neil B, et al. Safety and efficacy of pembrolizumab in advanced, programmed death Ligand 1-positive cervical cancer: Results from the Phase Ib KEYNOTE-028 Trial. J Clin Oncol. 2017 Dec 20;35(36):4035-4041
Chung H, Delord J-P, Perets R, et al. Pembrolizumab treatment of advanced cervical cancer: Updated results from the phase II Keynote-158 study. Gyn Oncol. 2021; 162 (1):s27
Tewari KS, Monk BJ, Vergote I, et al. Survival with cemiplimab in recurrent cervical cancer. New Engl J Med. 2022; 386: 544-555
Colombo N, Dubot C, Lorusso D, et al. Pembrolizumab for persistent, recurrent or metastatic cervical cancer. N Engl J Med. 2021; 385:1856-1867
Vergote I, Monk BJ, O’Cearbhaill RE, et al. Tisotumab vedotin (TV) + carboplatin (carbo) in first-line (1L) or + pembrolizumab (pembro) in previously treated (2L/3L) current or metasatic cervical cancer: Interim results from ENGOT-cx8/GOG-3024/innovaTV 205. Ann Oncol. 2021; 32 (suppl 5): S725
Vergote I, Mirza MR, Sehouli J, et al. Trial in progress update on ENGOT-cx8/GOG-3024/novaTV205 addition of a new cohort with first-line (1L) tisotumab vedotin (TV) + pembrolizumab (pembro) + carboplatin (carbo) +/- bevacizumab (bev) recurrent metastatic cervical cancer. J Clin Oncol. 2022; 40 (16): TPS5603

Leave a Reply
You must be logged in to post a comment.